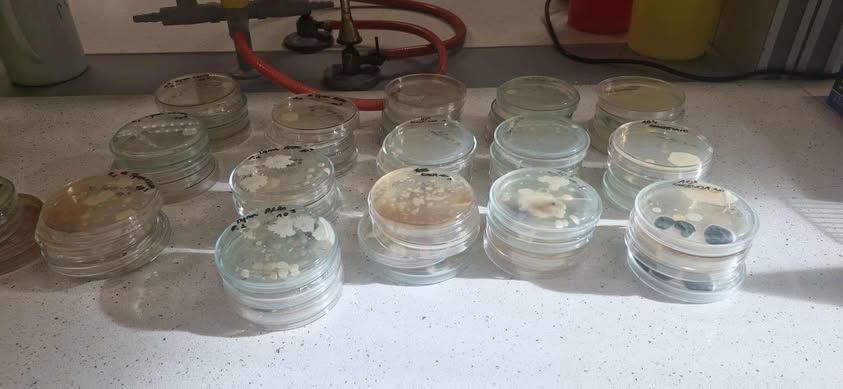
prace w laboratorium

Projekt „Miasto przyjazne dzieciom: badanie czystości mikrobiologicznej piaskownic w kontekście zdrowia publicznego i zrównoważonego rozwoju”
Miejskie piaskownice, intensywnie użytkowane przez dzieci, mogą kumulować zanieczyszczenia biologiczne (bakterie jelitowe, grzyby, jaja pasożytów), co stanowi potencjalne zagrożenie sanitarno-epidemiologiczne. Wyzwanie polega na uchwyceniu zmienności sezonowej i przestrzennej jakości piasku oraz rozróżnieniu źródeł skażenia (użytkownicy, zwierzęta, opady, brak rotacji piasku), przy jednoczesnym zapewnieniu porównywalności próbek i właściwej interpretacji wyników w kontekście ekspozycji dzieci.
Próbki z min. 5 miejskich piaskownic zostaną pobrane dwukrotnie: we wrześniu (po sezonie) i w kwietniu (początek sezonu). W laboratorium oznaczona zostanie ogólna liczba bakterii tlenowych mezofilnych oraz określona ogólna liczba grzybów, dodatkowo zostaną wykonane badania w kierunku obecności jaj pasożytów. Dla każdej piaskownicy udokumentowane zostaną cechy ekspozycji. Badania zostaną przeprowadzone zgodnie z obowiązującymi standardami, a wyniki przekazane w raporcie do Urzędu Miasta Łodzi.
Projekt ma charakter interdyscyplinarny, ponieważ łączy metody i perspektywy nauk biologicznych, zdrowia publicznego oraz zarządzania przestrzenią miejską. Problem będący jego przedmiotem wymaga wiedzy z zakresu mikrobiologii środowiskowej niezbędnej do oceny obecności drobnoustrojów i pasożytów w piasku. Jednocześnie projekt odnosi się do profilaktyki zdrowotnej oraz praktyki utrzymania infrastruktury rekreacyjnej, co wpisuje go także w obszary polityki komunalnej i urbanistyki.
Partnerem wiodącym projektu jest Wydział Zdrowia i Spraw Społecznych Urzędu Miasta Łodzi, realizujący zadania z zakresu ochrony zdrowia publicznego oraz wspierający działania na rzecz poprawy warunków życia mieszkańców, w tym bezpieczeństwa sanitarnego w przestrzeni miejskiej. Projekt będzie realizowany również we współpracy z Wydziałem Gospodarki Komunalnej UMŁ, który posiada doświadczenie w administracji samorządowej w obszarach gospodarki komunalnej, w szczególności utrzymania czystości, gospodarki odpadami oraz eksploatacji i rozwoju infrastruktury miejskiej. Wydział koordynuje zadania operacyjne i inwestycyjne, nadzoruje wykonawców i zamówienia, współpracuje międzywydziałowo oraz z miejskimi jednostkami organizacyjnymi. Zna procedury utrzymaniowe i standardy bezpieczeństwa sanitarnego na terenach miejskich, w tym w miejscach rekreacji dla dzieci.
Projekt „Miasto przyjazne dzieciom: badanie czystości mikrobiologicznej piaskownic w kontekście zdrowia publicznego i zrównoważonego rozwoju” jest ważną inicjatywą w kontekście celów zrównoważonego rozwoju, ponieważ poprzez działania na rzecz poprawy stanu sanitarnego miejskich piaskownic oraz zwiększenia bezpieczeństwa infrastruktury rekreacyjnej, projekt wspiera tworzenie zdrowszego i bardziej przyjaznego środowiska miejskiego dla wszystkich mieszkańców, w szczególności dzieci.
Projekt dotyczy realnego, lokalnego problemu sanitarnego w przestrzeni rekreacyjnej, który do tej pory nie był systematycznie monitorowany. Badania dostarczą praktycznych danych, wspierających decyzje Wydziału Zdrowia i Spraw Socjalnych. Projekt może stać się punktem wyjścia do dalszej współpracy między uczelnią a miastem w zakresie zarządzania jakością przestrzeni publicznej i działań profilaktyki zdrowotnej.
Zespół projektowy
- dr hab. Sylwia Różalska, prof. UŁ – mikrobiolożka, biotechnolożka związana z Uniwersytetem Łódzkim. Specjalizuje się w mikrobiologii środowiskowej i rolniczej. Prowadzi zajęcia dla studentów kierunków Biotechnologia i Mikrobiologia, łącząc podstawy mikrobiologii z praktycznymi metodami monitoringu i kontroli jakości środowiska. Jej celem jest przekładanie wyników badań na rekomendacje dla bezpieczeństwa publicznego i edukacji.
- prof. Tomislav Ivanković jest profesorem nadzwyczajnym mikrobiologii na Uniwersytecie w Zagrzebiu, specjalizującym się w badaniach nad biofilmami bakteryjnymi, oporności ą drobnoustrojów na antybiotyki, oczyszczaniu ścieków i bioremediacji. Kierował i współkierował projektami finansowanymi przez Chorwacką Fundację Naukową oraz francusko-chorwacki program „Cogito”, a jego działalność dydaktyczna i mentorska została doceniona kilkoma nagrodami. Jest autorem licznych publikacji z zakresu mikrobiologii środowiskowej, aktywnie wykłada i nadzoruje prace dyplomowe studentów.
- Katerina Roskach – studentka drugiego stopnia Biotechnologii Medycznej na Uniwersytecie Łódzkim. Szczególnie zainteresowana jest wykorzystaniem drobnoustrojów do produkcji wybranych związków oraz nowoczesnymi metodami diagnostyki i terapii chorób związanych z zakażeniem bakteryjnym w celu podniesienia bezpieczeństwa ludzi.
- Liubou Rabushka — studentka drugiego stopnia Biotechnologii Medycznej na Uniwersytecie Łódzkim. Koncentruje się na praktycznym wykorzystaniu narzędzi biotechnologii w celu podnoszenia jakości życia w środowisku miejskim oraz wzmacniania systemu ochrony zdrowia. Szczególnie interesują ją nowoczesne technologie biologiczne stosowane w diagnostyce, terapii i bezpieczeństwie zdrowotnym mieszkańców.
- Marta Stachowska - Studentka kierunku Biotechnologia oraz członkini Studenckiego Koła Naukowego Biotechnologiczno – Mikrobiologicznego „SKN Bio-Mik”, działającego przy Katedrze Mikrobiologii Przemysłowej i Biotechnologii Uniwersytetu Łódzkiego. Interesuje się praktycznym zastosowaniem wiedzy biotechnologicznej w celu poprawy jakości życia i bezpieczeństwa mieszkańców miasta.
- Patrycja Lemańska - studentka trzeciego roku Biotechnologii na Uniwersytecie Łódzkim oraz aktywna członkini Studenckiego Koła Naukowego Biotechnologiczno-Mikrobiologicznego. Jej zainteresowania naukowe koncentrują się wokół praktycznego wykorzystania drobnoustrojów – zarówno w produkcji innowacyjnych związków biologicznych, jak i w działaniach na rzecz poprawy jakości życia w środowisku miejskim oraz ochrony przyrody.
- Ines Bedeković - studiuje obecnie biologię na Uniwersytecie w Zagrzebiu. Interesuje się ogólnymi zastosowaniami mikroorganizmów w życiu codziennym, od produkcji żywności po wykorzystanie w biotechnologii. Interesuje się również organizmami chorobotwórczymi, a konkretnie badaniem mechanizmów, dzięki którym wywołują one choroby, a także metodami leczenia i zapobiegania.
Science Hub UniLodz (SH) to platforma współpracy Uniwersytetu Łódzkiego, która łączy osoby studiujące, uczelnianych ekspertów i ekspertki oraz podmioty zewnętrzne, wspierając ich w realizacji innowacyjnych projektów naukowych i wdrożeniowych. Zespoły działające w ramach SH wspólnie podejmują się rozwiązywania realnych wyzwań naukowych zgłaszanych przez organizacje partnerskie.
Konkurs Science Hub UniLodz – edycja UNIC jest realizowany w ramach projektu "We are UNIC!". Projekt „We are UNIC!” jest finansowany ze środków Unii Europejskiej w ramach programu „Support for European University Alliances”, projekt NAWA FERS.01.05-IP.08-0219/23, kwota: 62,705,297.60 zł.